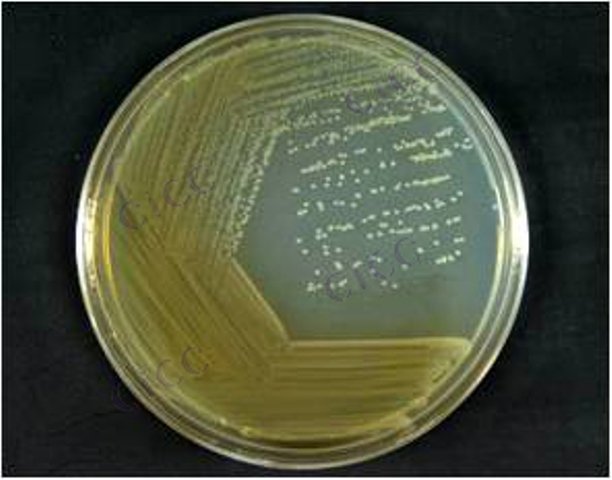
Acinetobacter parvus

Acinetobacter parvus
-
抗体anti-α-Parvin/PARVA Antibody, clone 3B5|Anti-α-Parvin/PARVA Antibody, clone 3B5|Sigma-Aldrich|25MIG 抗体anti-α-Parvin/PARVA Antibody, clone 3B5
Sigma-Aldrich-M#MABT1440-25UG | 25MIG
-
Blastomyces parvus
BNCC362481 | 斜面;菌液;平板
-
Penicillium parvum
CICC 41098 | 见证书
-
Acinetobacter hingginsii
BNCC370430 | 冻干粉;斜面;菌液;平板
-
Acinetobacter kanungonis
BNCC367812 | 冻干粉;斜面;菌液;平板
-
Acinetobacter baumannii
CICC 22933 | 见证书
-
Acinetobacter pittii
CICC 22934 | 见证书

说明书下载: 菌种说明书 打管说明书
您正在浏览的产品:细小不动杆菌 Acinetobacter parvus CICC 24011
手机版:细小不动杆菌 Acinetobacter parvus CICC 24011
本公司销售的所有产品仅供实验科研使用,不用于人体及临床诊断。